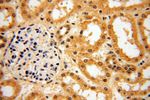
POLM Antibody in Immunohistochemistry (Paraffin) (IHC (P))

Search
Proteintech
POLM Polyclonal Antibody
{{$productOrderCtrl.translations['antibody.pdp.commerceCard.promotion.promotions']}}
{{$productOrderCtrl.translations['antibody.pdp.commerceCard.promotion.viewpromo']}}
{{$productOrderCtrl.translations['antibody.pdp.commerceCard.promotion.promocode']}}: {{promo.promoCode}} {{promo.promoTitle}} {{promo.promoDescription}}. {{$productOrderCtrl.translations['antibody.pdp.commerceCard.promotion.learnmore']}}
产品信息
14873-1-AP
种属反应
宿主/亚型
分类
类型
抗原
偶联物
形式
浓度
规格
纯化类型
保存液
内含物
保存条件
运输条件
产品详细信息
Immunogen sequence: MLPKRRRAR VGSPSGDAAS STPPSTRFPG VAIYLVEPRM GRSRRAFLTG LARSKGFRVL DACSSEATHV VMEETSAEEA VSWQERRMAA APPGCTPPAL LDISWLTESL GAGQPVPVEC RHRLEVAGPR KGPLSPAWMP AYACQRPTPL THHNTGLSEA LEILAEAAGF EGSEGRLLTF CRAASVLKAL PSPVTTLSQL QGLPHFGEHS SRVVQELLEH GVCEEVERVR RSERYQTMKL FTQIFGVGVK TADRWYREGL RTLDDLREQP QKLTQQQKAA PPGPEHPSPA VRCRCPAAGG GGSCGAGPAW GHRHADRRLP QGLILYHQHQ H (1-330 aa encoded by BC062590)
靶标信息
Gap-filling polymerase involved in repair of DNA double-strand breaks by non-homologous end joining (NHEJ). Participates in immunoglobulin (Ig) light chain gene rearrangement in V(D)J recombination.
仅用于科研。不用于诊断过程。未经明确授权不得转售。
篇参考文献 (0)
生物信息学
蛋白别名: DNA-directed DNA/RNA polymerase mu; Pol iota; Pol Mu; polymerase (DNA) mu; polymerase (DNA-directed), mu; Terminal transferase; unnamed protein product
基因别名: Pol Mu; POLM; polmu; Tdt-N
UniProt ID: (Human) Q9NP87
Entrez Gene ID: (Human) 27434